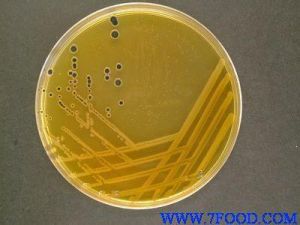
SS瓊脂 SS瓊脂

基礎培養基
| 配方 | g/L |
| 牛肉膏 | 5 |
| 脙腖 | 5 |
| 三號 膽鹽 | 3.5 |
| 瓊脂 | 17 |
溶於1000mL蒸餾水中混合均勻。121℃高壓滅菌15min,保存備用。
完全培養基
| 配方 | g/L |
| 牛肉膏 | 5 |
| 脙腖 | 5 |
| 三號 膽鹽 | 3.5 |
| 瓊脂 | 17 |
| 乳糖 | 10 |
| 檸檬酸鈉 | 8.5 |
| 硫代硫酸鈉 | 8.5 |
| 10% 檸檬酸鐵 溶液 | 10mL |
| 1% 中性紅 溶液 | 2.5mL |
| 0.1% 煌綠 溶液 | 0.33mL |
加熱溶化基礎培養基,按比例加入上述染料以外之各成分,充分混合均勻,校正至pH7.0,加入中性紅和煌綠溶液,傾注平板。
註:①制好的培養基宜當日使用,或保存於冰櫃內於48h內使用。
②煌綠溶液配好後應在10d以內使用。
③可以購用SS瓊脂的乾燥培養基。
原理
枸櫞酸鈉、膽鹽、硫代硫酸鈉的協同作用與煌綠共同來抑制腸道非病原性細菌及部分大腸埃希菌的生長;對志賀菌屬及沙門菌屬相對抑制性較弱。硫代硫酸鈉有助於大腸菌的菌落著色,枸櫞酸鐵能緩解某些藥物對病原菌的毒性作用,同時與細菌產物起反應呈黑色菌落。、中性紅可把分解乳糖和不分解乳糖的細菌鑑別開,前者為紅色菌落,後者為無色菌落,故此具有選擇性鑑別作用。